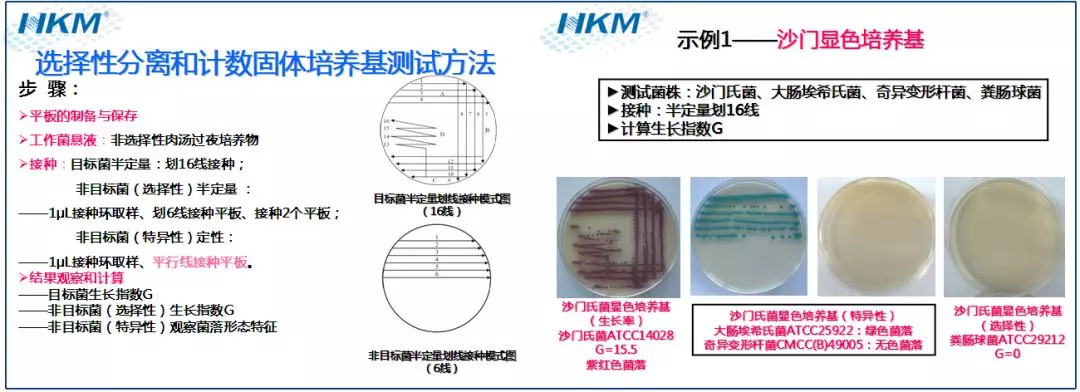
培養(yǎng)基質(zhì)量測試 培養(yǎng)基質(zhì)量測試

培養(yǎng)基配制方法和注意事項
發(fā)布時間:2019-09-02 瀏覽次數(shù):1685
正確制備培養(yǎng)基是微生物檢驗的最基礎(chǔ)步驟之一,使用脫水培養(yǎng)基和其他成分,尤其是含有有毒物質(zhì)(如膽鹽或其他選擇劑)的成分時,應(yīng)遵守良好實驗室規(guī)范和生產(chǎn)廠商提供的使用說明。培養(yǎng)基的不正確制備會導(dǎo)致培養(yǎng)基出現(xiàn)質(zhì)量問題。
使用商品化脫水合成培養(yǎng)基制備培養(yǎng)基時,應(yīng)嚴格按照廠商提供的使用說明配制。如重量(體積)、pH、制備日期、滅菌條件和操作步驟等。
實驗室使用各種基礎(chǔ)成分制備培養(yǎng)基時,應(yīng)按照配方準確配制,并記錄相關(guān)信息,如:培養(yǎng)基名稱和類型及試劑級別、每個成分物質(zhì)含量、制造商、批號、pH、培養(yǎng)基體積(分裝體積)、無菌措施(包括實施的方式、溫度及時間)、配置日期、人員等,以便溯源。
培養(yǎng)基的配制記錄
每次制備培養(yǎng)基均應(yīng)有記錄,包括培養(yǎng)基名稱,配方及其來源,和各種成份的牌號,最終pH值、消毒的溫度和時間制備的日期和制備者等,記錄應(yīng)復(fù)制一份,原記錄保存?zhèn)洳?,?fù)制記錄隨制好的培養(yǎng)基一同存放、以防發(fā)生混亂。
培養(yǎng)基的稱量和溶解
小心稱量所需量的脫水合成培養(yǎng)基(必要時佩戴口罩或在通風(fēng)柜中操作,以防吸入含有有毒物質(zhì)的培養(yǎng)基粉末),先加入適量的水,充分混合(注意避免培養(yǎng)基結(jié)塊),然后加水至所需的量后適當(dāng)加熱,并重復(fù)或連續(xù)攪拌使其快速分散,必要時應(yīng)完全溶解。含瓊脂的培養(yǎng)基在加熱前應(yīng)浸泡幾分鐘。
注意:培養(yǎng)基的加熱溶解或高溫滅菌盛放使用的容器不得為銅鍋或鐵鍋,以防有微量銅或鐵混入培養(yǎng)基中,使細菌不易生長。最好使用不銹鋼鍋加熱溶化,可放入大燒杯或大燒瓶中置高壓蒸汽滅菌器或流動蒸汽消毒器中蒸煮溶化。在鍋中溶化時、可先用溫水加熱并隨時攪動、以防焦化、如發(fā)現(xiàn)有焦化現(xiàn)象、該培養(yǎng)基即不能使用,應(yīng)重新制備。
PH的測定和調(diào)整
用pH計測pH,必要時在滅菌前進行調(diào)整,除特殊說明外,培養(yǎng)基滅菌后冷卻至25 ℃時,pH應(yīng)在標準pH±0.2范圍內(nèi)。一般使用濃度約為40 g/L(約1 mol/L)的氫氧化鈉溶液或濃度約為36.5 g/L(約1mol/L)的鹽酸溶液調(diào)整培養(yǎng)基的pH。如需滅菌后進行調(diào)整,則使用滅菌或除菌的溶液。
培養(yǎng)基的分類
培養(yǎng)基的分裝,應(yīng)按使用的目的和要求,分裝于試管、燒瓶等適當(dāng)容器內(nèi)。分裝量不得超過容器裝盛量的2/3。容器口可用墊有防濕紙的棉塞封堵,其外還須用防水紙包扎(現(xiàn)試管一般多有用螺旋蓋者)。分裝時最好能使用半自動或電動的定量分裝器。分裝瓊脂斜面培養(yǎng)基時,分裝量應(yīng)以能形成2/3底層和1/3斜面的量為洽當(dāng)。分裝容器應(yīng)預(yù)先清洗干凈并經(jīng)干烤消毒,以利于培養(yǎng)基的徹底滅菌。每批培養(yǎng)基應(yīng)另外分裝20ml培養(yǎng)基于一小玻璃瓶中,隨該批培養(yǎng)基同時滅菌,以為測定該批培養(yǎng)基最終pH之用。

培養(yǎng)基的滅菌
一般培養(yǎng)基可采用121°C高壓蒸汽滅菌15分鐘的方法。在各種培養(yǎng)基制備方法中,如無特殊規(guī)定,即可用此法滅菌。
某些熱敏成分,如糖類,應(yīng)另行配成20%或更高的濃液,以過濾或間歇滅菌法消毒,以后再用無菌操作技術(shù)、定量加于培養(yǎng)基。明膠培養(yǎng)基亦應(yīng)用較低溫度滅菌。血液、體液和抗生素等則應(yīng)以無菌操作技術(shù)抽取和加入于經(jīng)冷卻約50°C左右的培養(yǎng)基中。瓊脂斜面培養(yǎng)基應(yīng)在滅菌后立即取出,冷至55℃-60℃時,擺置成適當(dāng)斜面,待其自然凝固。
培養(yǎng)基的質(zhì)量測試
參見GB4789.28-2013 第6部分 培養(yǎng)基和試劑性能測試方法。通過生物學(xué)指標來評估培養(yǎng)基的質(zhì)量。

培養(yǎng)基的保存
商品化的培養(yǎng)基應(yīng)按照廠商提供的說明使用。每批培養(yǎng)基均必須附有該批培養(yǎng)基制備記錄副頁或明顯標簽。
